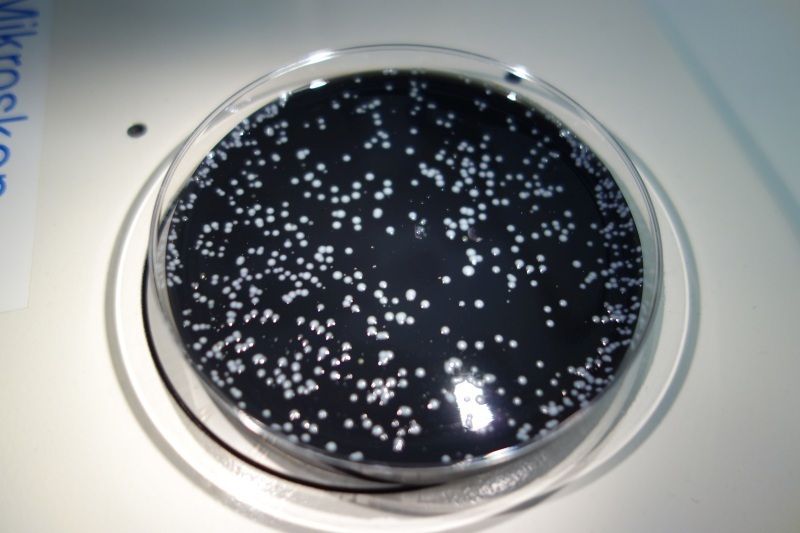

Trinkwasserbefund Teil 3 von 3
Ein Wasser kann unmöglich auf sämtliche Krankheitserreger hin untersucht werden. Aus diesem Grund wird eine Untersuchung über sogenannte "Indikatororganismen" vorgenommen. Wenn solche Keime nachgewiesen werden, kann das Vorhandensein von Krankheitserreger nicht mehr ausgeschlossen werden.

Koloniezahl bei 22° und 37°
Die Koloniezahl beschreibt die Summe aller vermehrungsfähigen Bakterien, Hefen, Schimmelpilzen etc. in der Wasserprobe. Eine gewisse Koloniezahl ist im Wasser fast immer natürlich vorhanden.
Eine erhöhte Koloniezahl deutet auf eine beginnende Verschmutzung oder auf eine zufällige Verunreinigung hin.
So wird im Trinkwasserlabor vorgegangen:
Eine erhöhte Koloniezahl deutet auf eine beginnende Verschmutzung oder auf eine zufällige Verunreinigung hin.
So wird im Trinkwasserlabor vorgegangen:
- Die Wasserprobe wird in einem Brutschrank erwärmt (22°C, 37°C) und 48 bis 72 Stunden bebrütet.
- Aus einzelnen Keimen, die ja unsichtbar sind, entwickeln sich Kolonien, die mit dem freien Auge erkennbar sind.
- Diese Bakterienkolonien werden sodann gezählt.
Coliforme Keime
Diese Keime stammen in erster Linie von Menschen und Tieren. Sie vermehren sich aber auch in der freien Natur. Coliforme Keime können sich auch in Wasseraufbereitungsanlagen oder Wasserfiltern ansiedeln und dort weiter vermehren. Im Falle einer Überschreitung des Indikatorparameterwertes (also des Richtwertes) soll die Ursache ermittelt werden. Darf angenommen werden, dass die Keime nicht auf fäkale Ursachen zurückzuführen sind, wird eine gewisse Überschreitung zulässig sein.

Escherichia Coli (e.coli) und Enterokokken
Diese Keime zeigen fäkale Verunreinigungen, da sie aus dem Darm von Menschen oder Tieren stammen. Sie deuten auf wildlebende Tiere, animalische Düngung oder Viehweide im Einzugsgebiet hin.
Sie treten im Wasser auch auf, wenn Tiere wie z.B. Mäuse, Schnecken oder Ameisen in den Brunnen fallen.
Enterokokken können im Wasser länger als Escherichia Coli überleben. Wenn nur Enterokokken, aber keine Escherichia-Coli nachgewiesen werden, deutet dies auf eine länger zurückliegende Verunreinigung hin. In warmen Perioden sind manchmal auch Insekten (Stechmücken) für einen Eintrag verantwortlich. Die Anlage muss also insektensicher ausgeführt sein.
Werden diese Bakterien nachgewiesen, muss das Wasser vor der Verwendung mindestens drei Minuten lang siedend abgekocht werden. Außerdem muss die Wasserversorgungsanlage umgehend auf eventuelle Mängel hin untersucht werden
Enterokokken können im Wasser länger als Escherichia Coli überleben. Wenn nur Enterokokken, aber keine Escherichia-Coli nachgewiesen werden, deutet dies auf eine länger zurückliegende Verunreinigung hin. In warmen Perioden sind manchmal auch Insekten (Stechmücken) für einen Eintrag verantwortlich. Die Anlage muss also insektensicher ausgeführt sein.
Werden diese Bakterien nachgewiesen, muss das Wasser vor der Verwendung mindestens drei Minuten lang siedend abgekocht werden. Außerdem muss die Wasserversorgungsanlage umgehend auf eventuelle Mängel hin untersucht werden
Clostridium perfringens und Pseudomonas aeruginosa
Clostridium perfringens
Dieses Darmbakterium dient zum Nachweis der Wirkung von Aufbereitungsgeräten und Desinfektionsanlagen.
Pseudomonas aeruginosa
Dieses Bakterium kommt in geringer Menge in Wässern vor. In Filteranlagen sowie in längeren Leitungsnetzen könnte sich dieses Bakterium dann stark vermehren und zu Problemen führen. Mithilfe dieser Organismen wird ebenfalls die Wirksamkeit von Aufbereitungsanlagen überprüft.
Dieses Darmbakterium dient zum Nachweis der Wirkung von Aufbereitungsgeräten und Desinfektionsanlagen.
Pseudomonas aeruginosa
Dieses Bakterium kommt in geringer Menge in Wässern vor. In Filteranlagen sowie in längeren Leitungsnetzen könnte sich dieses Bakterium dann stark vermehren und zu Problemen führen. Mithilfe dieser Organismen wird ebenfalls die Wirksamkeit von Aufbereitungsanlagen überprüft.
Buchtipp
Im Buch Eigenes Wasser für Haus und Hof wird das Thema Wasser umfangreich beleuchtet. Es beinhaltet viele Tipps, eine Anlage richtig herzustellen, bestehende Probleme richtig zu erkennen und mit einfachen Mitteln zu verbessern.